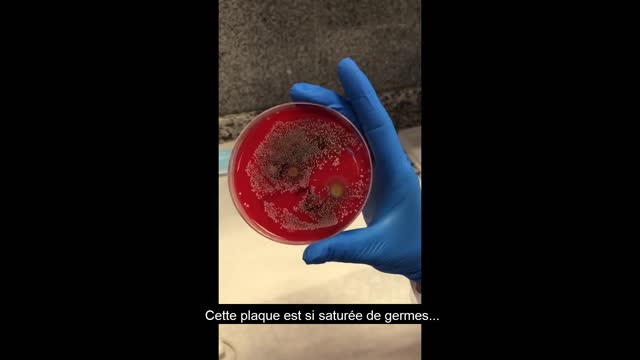

Premium Only Content
This video is only available to Rumble Premium subscribers. Subscribe to
enjoy exclusive content and ad-free viewing.
MICROBIOLOGIE - Une très curieuse culture (VOSTFR)
4 years ago
MICROBIOLOGIE - Une très curieuse culture (VOSTFR) - MICROBIOLOGÍA Un cultivo muy interesante (Marisa García Alonso)
Loading comments...
-
DVR
Flyover Conservatives
22 hours agoSatan’s Agenda vs. God’s Timeline: Witchcraft, Israel, and the Assassination of Charlie Kirk w/ Robin D. Bullock and Amanda Grace | FOC Show
25.1K10 -
LIVE
PandaSub2000
5 days agoLIVE 10pm ET | BYE SWEET CAROLE (The Disney'ish Horror Game)
213 watching -
1:22:51
Glenn Greenwald
7 hours agoThe Irony of John Bolton's Classified Docs Indictment; Prominent Dems Now Stutter When Asked About AIPAC; Celebs in Saudi Arabia Controversy: What Does it Reveal? | SYSTEM UPDATE #532
77.7K46 -
39:25
Donald Trump Jr.
6 hours agoFBI's Incredible Crime Crackdown, Plus my Message to ABC!! | TRIGGERED Ep.283
134K109 -
2:53:38
BigTallRedneck
5 hours agoPGA 2K25 - REDNECK'S WAY OR THE HIGHWAY
7.35K -
2:43:58
megimu32
4 hours agoON THE SUBJECT: MTV | From 24/7 Music to… Silence?
5.47K5 -
4:38:09
Reolock
5 hours agoWoW Classic Hardcore | More Ultra? Maybe Mage?
3.28K -
1:02:05
BonginoReport
7 hours agoMusic Stars Go Viral For Anti-ICE Rants - Nightly Scroll w/ Hayley Caronia (Ep.157)
72.3K42 -
3:57:04
Amish Zaku
6 hours agoBaldur's Gate 3 - Four Player Co-op Act 3
1.81K -
LIVE
Barry Cunningham
4 hours agoKINDA BREAKING NEWS! JOHN BOLTON HAS BEEN INDICTED! WHO'S NEXT!
3,948 watching